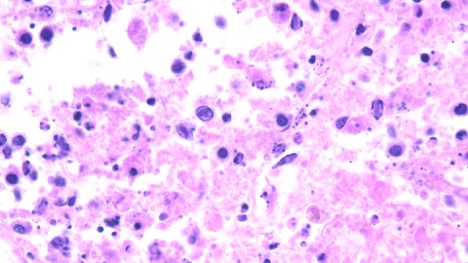
histology capture

Tularemia in a Juvenile Feral Cat
Tularemia is a highly infectious, zoonotic disease caused by the bacterium Francisella tularensis. Rodents and rabbits are particularly susceptible to infection and can transmit the disease to humans or domestic animals through direct contact. Other routes of exposure include tick and deer fly bites, drinking contaminated water, or inhaling contaminated dust or aerosols. Because of its potential use as an agent of bioterrorism, tularemia is considered a federal select agent.
Outdoor cats are typically infected by hunting/consuming infected rodents, hares, or rabbits which results in the ulceroglandular or oropharyngeal form of the disease. Typical clinical signs include high fever, anorexia, skin or oral ulceration, and regional lymph node swelling. Infection may cause acute death within days or become chronic with persistent, mild clinical signs. Yersinia pestis (plague) has a similar clinical presentation but is more common in the southwestern United States, while tularemia is most prevalent in the south-central United States (Missouri, Kansas, Arkansas, and Oklahoma).
History and Signalment
A five-month-old female cat from a feral colony was presented to the MU VMDL for necropsy examination. The cat had a two-day history of anorexia and reclusive behavior. Increased vocalization and weakness/ataxia were also noted prior to death.
Diagnostics and Necropsy Findings
Rabies was ruled out prior to necropsy by fluorescent antibody testing at the Missouri Department of Health and Senior Services laboratory.
At necropsy, the submandibular, pancreatic, and ileocolic lymph nodes were enlarged with multifocal to coalescing 1 mm tan-yellow nodules giving the nodes a diffusely cobblestone-like texture. There were also multifocal 1 to 2 mm, well-demarcated, slightly raised, tan nodules throughout all lung lobes, liver, and spleen.

Histopathology confirmed necrosis in the lymph nodes, spleen, lung, and liver. Real-time PCR testing for Francisella tularensis at a referral laboratory was positive.
Tularemia suspects should not be necropsied in the field due to the zoonotic disease risk. If you have a tularemia suspect case, submit the whole carcass to the VMDL for necropsy and be sure to mention your suspicion, so that we can take appropriate precautions.
Canine Brucellosis Testing at the VMDL
Canine brucellosis is a leading cause of reproductive failure in dogs. While some animals may be asymptomatic, clinical signs of the reproductive disease include enlarged testicles and infertility in males, and embryonic or mid- to late-term abortion in females.
There is currently no effective course of treatment for canine brucellosis, which underscores the need for strong biosecurity measures to prevent the introduction and spread of the disease, particularly in highly populated environments (e.g., breeding kennels, shelters). Canine brucellosis also poses a risk to human health, as thecausative agent, Brucella canis, and other Brucella species are zoonotic pathogens.
The gold standard for diagnosing canine brucellosis is isolation of the bacterium, B. canis, from a blood culture. However, serologic tests are primarily used to screen for antibodies against the bacterium as they are much faster and generally more sensitive tests. Blood cultures are required to confirm suspect serological results.
The University of Missouri VMDL previously used a rapid lateral flow assay, but this test is no longer commercially available. The Serology section has explored other testing options and recently began validating an enzyme-linked immunosorbent assay (ELISA) that will return fast results for our clients. This test is expected to be offered beginning Spring 2026 and will have a turnaround time of 1–3 business days.
Canine brucellosis is a reportable disease in Missouri. Any suspect results will be forwarded to the Missouri Department of Agriculture for additional testing.
For questions on canine brucellosis testing, please contact the University of Missouri VMDL.

Goat Abortion due to Caprine Herpesvirus
Caprine herpesvirus 1 causes sporadic outbreaks of late-term abortions in goats. As with all herpesviruses, goats can become latently infected and experience recrudescence with shedding in times of stress. While abortion is often the only clinical sign, CHV-1 can cause other reproductive and respiratory symptoms in infected adult goats. No commercially licensed vaccines are currently available in the USA.
History and Signalment
Three caprine fetuses presented to the MU VMDL for necropsy and full abortion workup. The herd had been experiencing late-term abortions for the last four weeks, totaling approximately 14 lost pregnancies. The owner reported seeing brown vulvar discharge prior to abortion in several does.
Diagnostics and Necropsy Findings
No apparent abnormalities were noted grossly. Gestational age was estimated at 119-150 days. Histopathology revealed multifocal necrosis and inflammation of the lung and thymus with intranuclear inclusion bodies in all three fetuses.
The intranuclear inclusion bodies were highly suggestive of caprine herpesvirus 1 infection. All other ancillary testing (culture and PCR) was negative.

Annual MVMA Meeting in Columbia, MO
It was wonderful seeing all of you at the MVMA Meeting this year! Thank you to everyone who participated in our CE sessions, tours, and wet lab and stopped by our booth in the exhibit hall. See you again next year!
